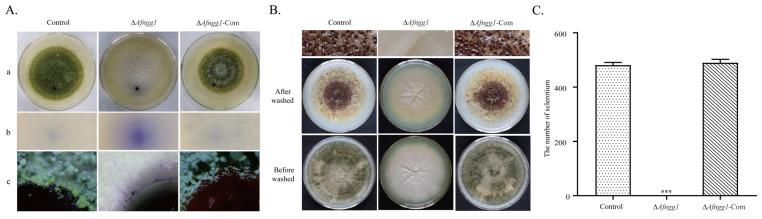
https://cdn.ncbi.nlm.nih.gov/pmc/blobs/a195/9861817/ef32e42a038d/toxins-15-00007-g003.jpg

组蛋白 2-羟异丁酰基转移酶编码基因 参与 的致病性和黄曲霉毒素生物合成。
Histone 2-Hydroxyisobutyryltransferase Encoded by Is Involved in Pathogenicity and Aflatoxin Biosynthesis in .
机构信息
College of Biological Engineering, Henan University of Technology, Zhengzhou 450001, China.
Henan Provincial Key Laboratory of Biological Processing and Nutritional Function of Wheat, Zhengzhou 450001, China.
出版信息
Toxins (Basel). 2022 Dec 21;15(1):7. doi: 10.3390/toxins15010007.
Aflatoxin, a carcinogenic secondary metabolite produced by , is a significant threat to human health and agricultural production. Histone 2-hydroxyisobutyrylation is a novel post-translational modification that regulates various biological processes, including secondary metabolism. In this study, we identified the novel histone 2-hydroxyisobutyryltransferase Afngg1 in , and explored its role in cell growth, development and aflatoxin biosynthesis. gene deletion markedly decreased lysine 2-hydroxyisobutyrylation modification of histones H4K5 and H4K8 compared with the control strain. Additionally, deletion inhibited mycelial growth of , and the number of conidia and hydrophobicity were significantly decreased. Notably, aflatoxin B biosynthesis and sclerotia production were completely inhibited in the Δ strain. Furthermore, the pathogenicity of the Δ strain infecting peanut and corn grains was also diminished, including reduced spore production and aflatoxin biosynthesis compared with control and complementation strains. Transcriptome analysis showed that, compared with control strains, differentially expressed genes in Δ were mainly involved in chromatin remodelling, cell development, secondary metabolism and oxidative stress. These results suggest that Afngg1 is involved in histone 2-hydroxyisobutyrylation and chromatin modification, and thus affects cell development and aflatoxin biosynthesis in . Our results lay a foundation for in-depth research on the 2-hydroxyisobutyrylation modification in , and may provide a novel target for aflatoxin contamination prevention.
黄曲霉毒素是一种由真菌产生的致癌次级代谢产物,对人类健康和农业生产构成重大威胁。组蛋白 2-羟基异丁酰化是一种新的翻译后修饰,调节包括次级代谢在内的各种生物过程。在这项研究中,我们在真菌中鉴定了新型组蛋白 2-羟基异丁酰基转移酶 Afngg1,并探讨了其在细胞生长、发育和黄曲霉毒素生物合成中的作用。与对照菌株相比,基因缺失显著降低了组蛋白 H4K5 和 H4K8 的赖氨酸 2-羟基异丁酰化修饰。此外,缺失抑制了真菌的菌丝生长,分生孢子的数量和疏水性显著降低。值得注意的是,Δ菌株中的黄曲霉毒素 B 生物合成和菌核生成完全受到抑制。此外,与对照和互补菌株相比,Δ菌株感染花生和玉米粒的致病性也降低,包括孢子产生和黄曲霉毒素生物合成减少。转录组分析表明,与对照菌株相比,Δ中的差异表达基因主要参与染色质重塑、细胞发育、次级代谢和氧化应激。这些结果表明,Afngg1 参与组蛋白 2-羟基异丁酰化和染色质修饰,从而影响真菌中的细胞发育和黄曲霉毒素生物合成。我们的研究结果为深入研究真菌中的 2-羟基异丁酰化修饰奠定了基础,并可能为预防黄曲霉毒素污染提供新的靶点。